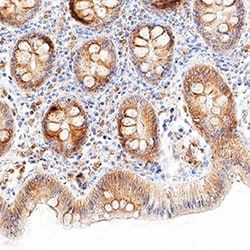

AF20451
17017-91-3 | 5-sulfaminouracil
Manufacturer: A2B Chem
CAS Number: 17017-91-3
Select a Size
| Pack Size | SKU | Availability | Price |
|---|---|---|---|
| 50mg | AF20451-50mg | In Stock | ₹ 46,369.00 |
| 100mg | AF20451-100mg | In Stock | ₹ 62,300.00 |
| 250mg | AF20451-250mg | In Stock | ₹ 82,859.00 |
AF20451 - 50mg
In Stock
Quantity
1
Base Price: ₹ 46,369.00
GST (18%): ₹ 8,346.42
Total Price: ₹ 54,715.42
Catalog Number
AF20451
Chemical Name
5-sulfaminouracil
Cas Number
17017-91-3
Molecular Formula
C4H5N3O4S
Molecular Weight
191.1652
Mdl Number
MFCD00791450
Smiles
O=c1[nH]c(=O)[nH]cc1S(=O)(=O)N
Other Options
| Image | Product Name | Manufacturer | Price Range | |
|---|---|---|---|---|
 | 2,4-Dioxo-1,2,3,4-tetrahydropyrimidine-5-sulfonamide | ChemScene | ₹ 1,54,237.00 - ₹ 2,56,854.00 |